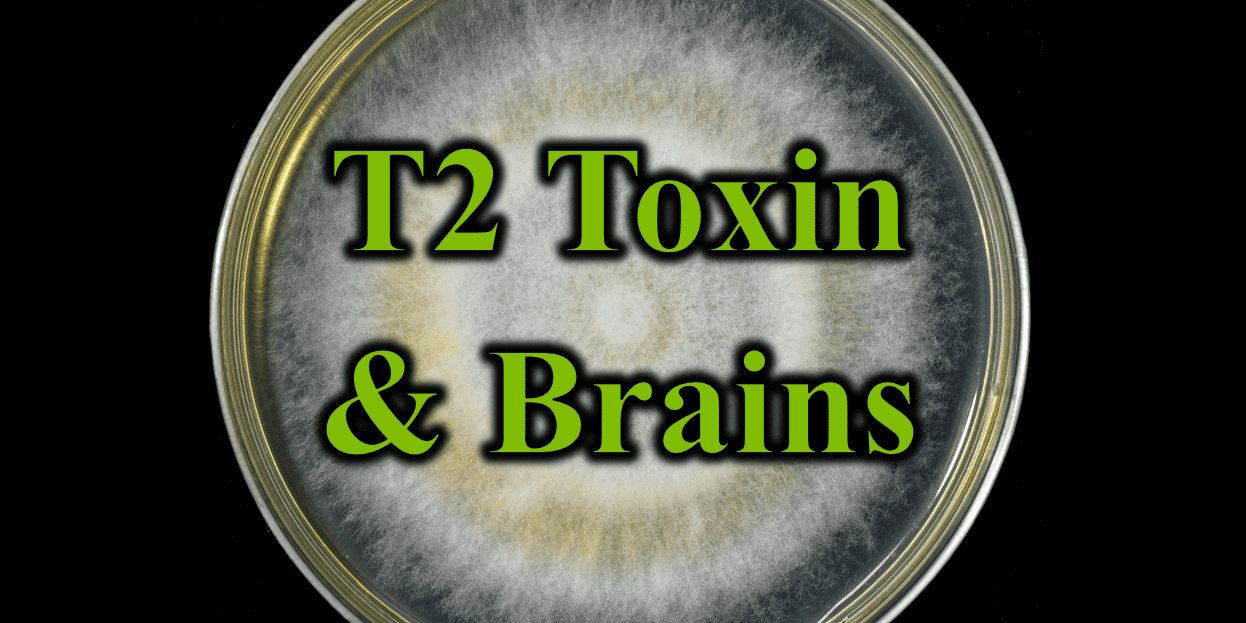

Much debate exists over the effects of mold toxins or mycotoxins on the health of humans in water damaged buildings. Despite the plethora of animal research and the multitudes of patients with clear cases of mold toxicity, the wider medical world has its doubts. They must admit the more unusual cases of third world food poisoning which occurs from moldy foods but can’t wrap their brains around the potential for transdermal or inhalational exposures. While this could be written off as just another animal study, this research indicates that transdermal or subcutaneous (injected under skin) doses of a Fusarium tricothecene toxin called T-2 can influence inflammation in the brains of experimental mice.
The mold itself, Fusarium is better known for its growth on plants such as grains and vegetables. Different species of Fusarium grow on a variety of plants causing a variety of plant diseases. It resides in the soil and is spread to plants. Beyond these potentially ingested sources, Fusarium can also live on building materials (Lindemann et al., 2022; Anderson et al., 2011; Habibi, A. & Safaiefarahani B. 2018) as several studies indicate and many websites mention presence in indoor environments without listing citations. This mold species produces a number of different toxins (including the trichothecene T-2 toxin. zearalenone, deoxynivalenol (DON), enniatin, and fumonisins) can be produced by Fusarium (Hope 2013; Munkvold 2017).
The T-2 toxin belongs to the tricothecene group with a ring structure. Other tricothecenes are produced by other molds like Myrothecium and Stachybotrys. T-2 is one of the most important agricultural mycotoxins (Adhikari et al. 2017). The first recognized outbreak of T-2 toxin poisoning occurred in Orenburg, Russia during World War II when a large number of civilians died from contaminated grain ingestion (Adhikari et al. 2017). The T-2 toxin was identified 20 years later (Afsah-Hejri, 2013). The trichothecene toxin group are known to enter the body through topical, oral, or inhalational routes (Adhikari et al. 2017). While the resulting symptoms depend on the route of intoxication, they include alimentary toxic aleukia, local irritant effects like blistering, hemorhaggic inflammation, necrosis or ulceration of the GI tract, “dystrophy in liver kidney, heart, brain and peripheral nervous system, and damage to blood vessel walls. Mechanisms include alterations in energy metabolisms, increased oxidative stress, changes in brain neurotransmitters, DNA damage and more. (Adhikari et al. 2017). In situations of chronic exposure, animals were found to exhibit weight loss, low blood sugar, liver changes, decreased blood cell counts and other symptoms. (Adhikari et al. 2017).
In the present study, mice either had the toxin placed on their skin or injected under their skin. They were killed and examined at different times following this application of toxin. Over succeeding days, the levels of reactive oxygen species increased while glutathione levels decreased. Lipid peroxidation rose in the mice brains indicating oxidative stress damage. Gene expressions for antioxidant enzymes changed and the anti-inflammatory pathway of NrF2 was downregulated. Several other genes for detoxification were decreased as well. Thus, topical or subcutaneous injection of T-2 toxin clearly produced oxidative stress damage in the brains of the mice. This is thought to be partially due to an increase in blood-brain barrier permeability or leaky brain.
These finding are not surprising. We see neurologic effects of mold toxins in our mold toxic patients on a daily basis. Sometimes, these effects may be mediated through other dysfunctions like hormones, the immune system, or other systems. However, this study indicates that sometimes the effects are directly upon the brain. Helping our patients live healthier more abundant lives requires awareness of all the possible mechanisms so we can target both the removal of the toxins and the recovery of proper functioning.
Focus Article:
Chaudhary, M., & Rao, P. V. (2010). Brain oxidative stress after dermal and subcutaneous exposure of T-2 toxin in mice. Food and chemical toxicology : an international journal published for the British Industrial Biological Research Association, 48(12), 3436–3442. https://doi.org/10.1016/j.fct.2010.09.018
Bibliography:
Afsah-Hejri L, Jinap S, Hajeb P, Radu S, Shakibazadeh SH. A review on mycotoxins in food and feed: Malaysia case study. Compr Rev Food Sci F. 2013;12:629–651.
Andersen B, Frisvad JC, Søndergaard I, Rasmussen IS, Larsen LS. Associations between fungal species and water-damaged building materials. Applied and Environmental Microbiology. 2011 Jun;77(12):4180-4188. DOI: 10.1128/aem.02513-10. PMID: 21531835; PMCID: PMC3131638.
Janette Hope, “A Review of the Mechanism of Injury and Treatment Approaches for Illness Resulting from Exposure to Water-Damaged Buildings, Mold, and Mycotoxins”, The Scientific World Journal, vol. 2013, Article ID 767482, 20 pages, 2013. https://doi.org/10.1155/2013/767482
Lindemann, V., Schleiner, T., Maier, U., Fels, H., Cramer, B., & Humpf, H. U. (2022). Analysis of mold and mycotoxins in naturally infested indoor building materials. Mycotoxin research, 38(3), 205–220. https://doi.org/10.1007/s12550-022-00461-3
Munkvold G. P. (2017). Fusarium Species and Their Associated Mycotoxins. Methods in molecular biology (Clifton, N.J.), 1542, 51–106. https://doi.org/10.1007/978-1-4939-6707-0_4
Sanctuary Functional Medicine, under the direction of Dr Eric Potter, IFMCP MD, provides functional medicine services to Nashville, Middle Tennessee and beyond. We frequently treat patients from Kentucky, Alabama, Mississippi, Georgia, Ohio, Indiana, and more... offering the hope of healthier more abundant lives to those with chronic illness.

Dr. Eric Potter graduated from Vanderbilt Medical School and then went on to specialize in internal medicine (adult) and pediatric care, spending significant time and effort in growing his medical understanding while caring for patients from all walks of life.